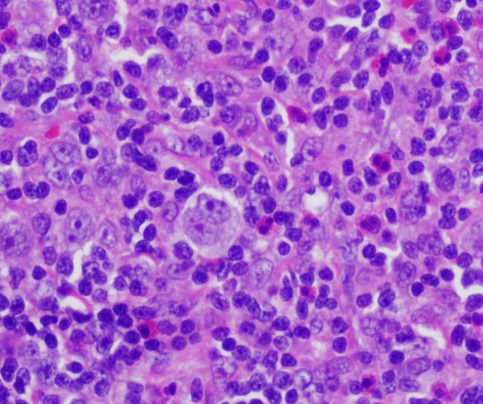
MDH-101 活检样本固定试剂盒(AZF法)

- 当前分类
- 子分类
- 品牌
其它
阿拉丁
zzstandard
medchemexpress(mce)
fujifilm wako
bestbio贝博
aat bioquest
zymo research
dojindo
adipogen
达优
vivacell
enzo
stressmarq
hkm/环凯
ibidi
cloud-clone
oxoid
chondrex
cayman
prozyme
fitzgerald
surmodics
invivogen
promocell
biovendor
strigolab
genecopoeia
neobioscience
武汉金开瑞生物工程有限公司
gibco
环凯生物
cellvis
bangs laboratories
mp biomedicals
selleck
apexbio
bd
millipore
cusabio
MDH-101 活检样本固定试剂盒(AZF法)
MDH-101 活检样本固定试剂盒(AZF法) 规格: 50x1.5ml /10x10ml /250ml/4x250ml 产品号: MDH-101 产品名称:GeneFresh Tissue AZF Fixative 品牌: MedHubExpressTM 生产商: 深圳艾德旺斯
品牌:GeneFresh货号:MDH-101A
¥500

羧基磁性微球
【英文名称】carboxylated magenetic microsphere 【成 分】Fe3O4、纯水 【性 状】黑色水溶液 【用 途】生物分子分离、构建磁性纳米药物等 【特 点】①高磁响应性(饱和磁化率50 emu/g),超顺磁性;②粒径分布均匀,水溶性,单分散性和稳定
品牌:百翱普世货号:MA01C
¥499

聚(L-丙交酯-己内酯)
聚(L-丙交酯-己内酯)(PLCL) 中文名称 聚(L-丙交酯-己内酯) Chemical Name POLY ( L-LACTIDE-CAPROLACTONE ) 产品型号Product Model PLCL 化学式Chemical Formula (C6H8O4*C6H10O
品牌:ECO货号:65408-67-5
¥120

高效DNA、RNA转染试剂
一、产品说明: 1、产品名称 Advanced DNA RNA Transfection Reagent 2、包装规格 货号:AD600025、AD600050、AD600075、AD600150 规格:0.25ml、0.5ml、0.75ml、1.5ml 3、储存条件 常温运输,
品牌:ZETA LIFE货号:AD600075
¥1590-4490

5号工业级白油
白油的产品有很多的型号,欢迎来到星燃石化丁香通网站,这里主要介绍5号工业级白油,星燃石化,这个企业是一家以“互联网+”为号召的多元化的新媒体石油化工企业。星燃石化公司自主研发在线下单平台,为客户提供线上的下单、查账、开票等便捷服务。拥有近百位资深销售精英及专职的客服团队,可为客户
品牌:茂石化货号:5#
¥5000

真菌染色液妇科白带染色液革兰染色液巴氏染色液抗酸染色液H-E染色液乳酸棉酚蓝染液
乳酸棉酚蓝染液 [检验原理]霉菌菌丝较粗大,细胞易收缩变形,且孢子容易飞散,所以制标本时常用乳酸-石-炭-酸-棉蓝染色液。此染色液制成的霉菌标本片的特点是:细胞不变形,具有杀菌防腐作用,且不易干燥,能保持较长时间,溶液本身呈蓝色,有一定染色效果。 [组成]:石-炭-酸,乳酸,甘油
品牌:IVD货号:312183
¥500

硅胶 923 GRACE(烃组份分析 GB/T11132) Silica gel grade 923
硅胶 923 ASTM D1319 HP 500G GRACE 100-200目 烃组份分析 GB/T11132
品牌:GRACE货号:ASTM D1319
¥1280

高倍率高清晰正置金相显微镜
系统组成 电脑型金相显微镜:1、金相显微镜2、适配镜 3、器(CCD) 4、A/D(图像采集) 5、计算机 数码相机型金相显微镜:1、金相显微镜 2、适配镜 3、数码相机 特点特性 金相学主要指借助光学(金相)显微镜和体视显微镜等对材料显微组织、低倍组织和断口组织等进行分析研究和
品牌:力创货号:40
¥9999

高流量呼吸机推车B超心电监护远程医疗工作站台车
高流量呼吸机推车B超心电监护远程医疗工作站台车 主体结构采用优质铝合金材料,结构可靠,使用灵活方便。用于医院病房、手术室、急救中心、体检中心、计算机机房等单位。用于移动式办公,查房等用途。 1.电脑手推车查房车功具有调阅电子病历、医嘱管理等功能,可兼容扫描、读码、打印等功能,医护
品牌:昌荣发货号:CRF0018
¥750

DPPH Free Radical 1,1-二苯基-2-苦基肼 5g CAS:1898-66-4
DPPH Free Radical 1,1-二苯基-2-苦基肼 5g CAS:1898-66-4 产品名称:1,1-二苯基-2-苦基肼 规格:5g
品牌:TCI货号:D4313-5g
¥2390

现货DNeasy Blood & Tissue Kit (250)69506 DNeasy血液组织试剂盒(50)
。大多数样本可直接用蛋白酶K消化处理,无需机械破碎,减少了手动操作时间。为特殊样本提供优化的纯化方法,获得高重复性、高纯度的DNA,用于生物研究、基因型分析和兽医病理研究。DNA纯化流程可以使用DNeasy Blood & Tissue Kit,在QIAcube全自动核酸纯化仪上自
品牌:QIAGEN货号:69506
¥1736-7400

pCXSN
业务电话:18576854185 QQ:2079952802 邮箱:runbobiological@163.com 产品说明: 保质期限:90天,请尽快转化。 保存温度:一般在-20℃,置于-80℃保存时间更长。 运输方式:常温运输,1周内。 注意事项:转化前请准确查找该质粒相应
品牌:润博(RBBT)货号:FF-ZT038
¥899

真空电机-真空模组专业应用真空室,高温室,高洁净度环境
真空电机-真空模组专业应用真空室,高温室,高洁净度环境 1.真空电机定义 真空电机是可以在真空环境里工作的电机,通常真空环境中没有热对流,只有热传导和辐射,故电机在真空中散热困难。所以该电机必须要抗辐射和耐高温,那么问题来了,从设计阶段就要考虑各种图层、材料、润滑等。再者应用环节
品牌:臻上机电ddon货号:6633
¥1688

净化室专用加压风柜,深圳洁净室中效加压风柜厂家
产品说明(咨询热线:13728744817/宋生) 增压风柜因其结构灵活紧凑,噪音低,运行平稳,风量风压可调性好,使用寿命长等特点,被广泛应用于民用建筑的通风系统中,同时还可应用到房屋建筑的消防加压送风,净化车间空调的增压补风等场合。 特点 增压风柜结构紧凑灵活,选材合理,确保机
品牌:雄海货号:XH456145
¥6500

RO-948 Opaque-Ink X射线医疗显影油墨
RO-948是一种溶剂型加热干燥油墨,用于需要在暴露于X射线和其他成像技术的设备上显示可见标签的应用 RO-948 is a solvent based, heat dried ink designed for use in applications requiring visi
品牌:RO-948 货号:Opaque-Ink
¥333

0.25%胰酶(不含EDTA、不含酚红)
胰酶细胞消化液(不含EDTA)含0.25%胰酶,不含EDTA。 该消化液经过0.22um滤器过滤除菌,可以直接用于培养细胞的消化,或者一些组织的消化。 本胰酶细胞消化液(不含EDTA)具有方便快速的特点,通常室温消化1分钟左右就可以消化下大多数贴壁细胞。 保存条件: 4℃保存,一
品牌:迎欣生物GZYXbio货号:SJ-CELL-001
¥30

Biocoat Matrigel 基质胶使用指南
产品特性 Martrigel 基质会有色差变化(淡黄色到深红色),是由于酚红和碳酸氢盐与 CO2 的作用引起 的,但是与 5%CO2 平衡后色差即会减少。 基质胶冻融操作 收货后,若不立刻使用基质胶,应马上将仍然是冷冻固态的基质胶放进-20℃冰箱保存。 使用前须先将基质胶冻融。
品牌:Corning货号:354234
¥2000

苯扎氯铵(季铵盐)
别名:洁尔灭、苯扎氯铵 技术指标:符合HG/T 2230—2006 英文名:Dodecyl Dimethyl Benzyl ammonium Chloride 1227 CAS No.139-07-1;8001-54-5 分子式:C21H38NCl 相对分子质量:340.00 项
品牌:应泓货号:1227
¥10500













